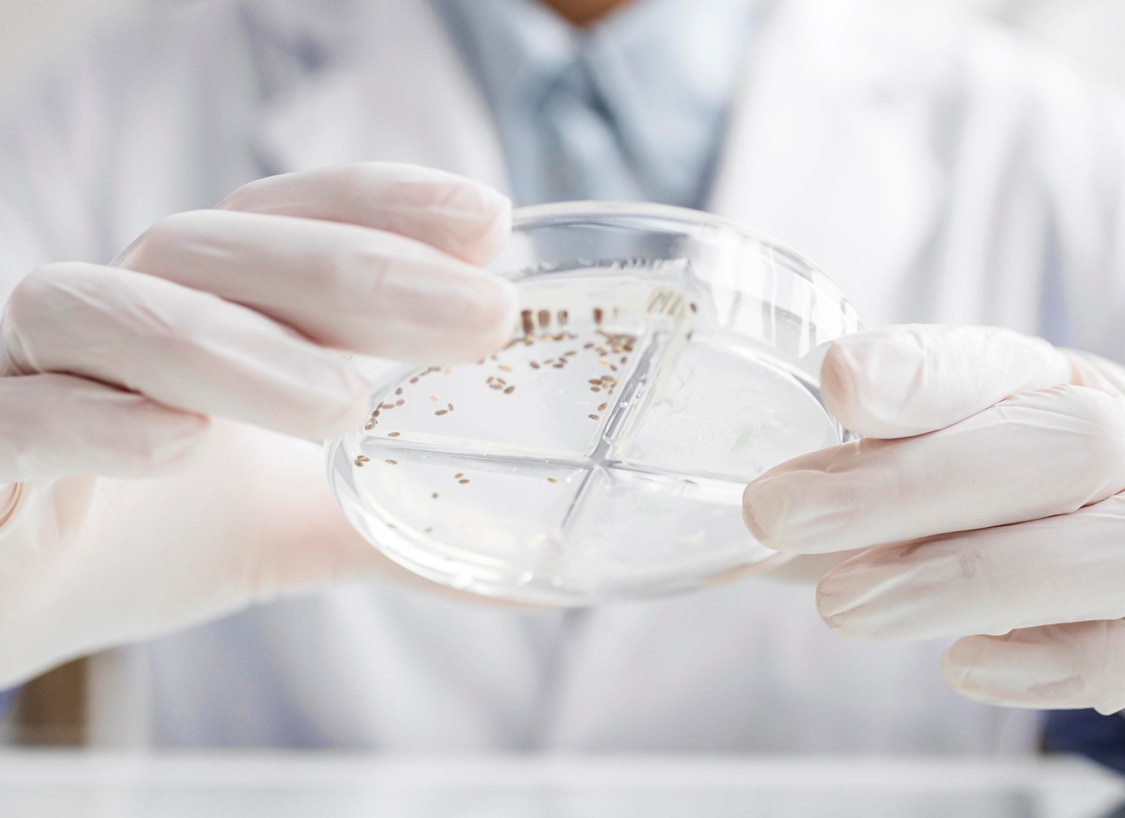

Австралийская биотехнологическая компания анонсировала возможную революцию в лечении
Компания Filamon Limited, австралийский клинический биотехнологический разработчик, объявила о значительном достижении в поисках эффективных методов лечения деменции. Компания разработала препарат ALPHA-003, который направлен на предотвращение повреждения мозга, связанного с деменцией, еще до того, как оно происходит.
Современные подходы к лечению деменции сосредоточены на минимизации последствий повреждения клеток мозга, однако Filamon предлагает новый подход, направленный на сохранение целостности микротрубочек мозговых клеток. Эти микротрубочки являются ключевыми для нормальной работы мозга, и их разрушение приводит к гибели мозговых клеток при деменции. ALPHA-003 стабилизирует тау-белки и нейрофиламенты, которые защищают микротрубочки от воспалительных повреждений.
Этот инновационный препарат способен проникать через гематоэнцефалический барьер, предоставляя уникальный механизм действия. ALPHA-003 разрабатывается для лечения тауопатий, включая болезнь Альцгеймера, фронтотемпоральную деменцию, прогрессивный супрануклеарный паралич и хроническую травматическую энцефалопатию (ЧТЭ), которая развивается в результате повторных сотрясений мозга. На сегодняшний день не существует препаратов, которые бы значимо замедляли прогрессирование этих нейродегенеративных заболеваний.
В настоящее время ALPHA-003 проходит доклинические испытания, и планируется, что клинические исследования начнутся в 2026 году. Этот прорыв может стать новой надеждой для пациентов с деменцией, особенно в условиях стареющего населения, где деменция становится ведущей причиной смертности и растущей нагрузкой на системы здравоохранения.
Инновационный подход Filamon представляет собой сдвиг от лечения последствий повреждения клеток мозга к профилактике их повреждения, что может стать важным шагом в лечении деменции.
Читать подробнее: https://filamon.com/wp-content/uploads/2024/11/Filamon-Dementia-Announcement.-FINAL-003.pdf